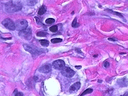
Rodrigue KONAN's avatar

Détails de l'organisations
GIC F Toula
Créée depuis 2 ans,
Follower(s)
Contact
| Téléphone: | N/A |
| Adresse: | Bafoussam IIIe, Cameroun |
| E-mail: | gic.f.toula@gmail.com |
| Site web: | N/A |
A propos
Groupe d'initiative commune spécialisé dans la transformation et le concervation des produits forestiers non ligneux tels que le biter cola, le pepper, le soc, le poivre, etc
Membres
Publications récentes
| Valide | Besoin/Offre | Produit | Titre |
|---|---|---|---|
| Pas de publication récente | |||